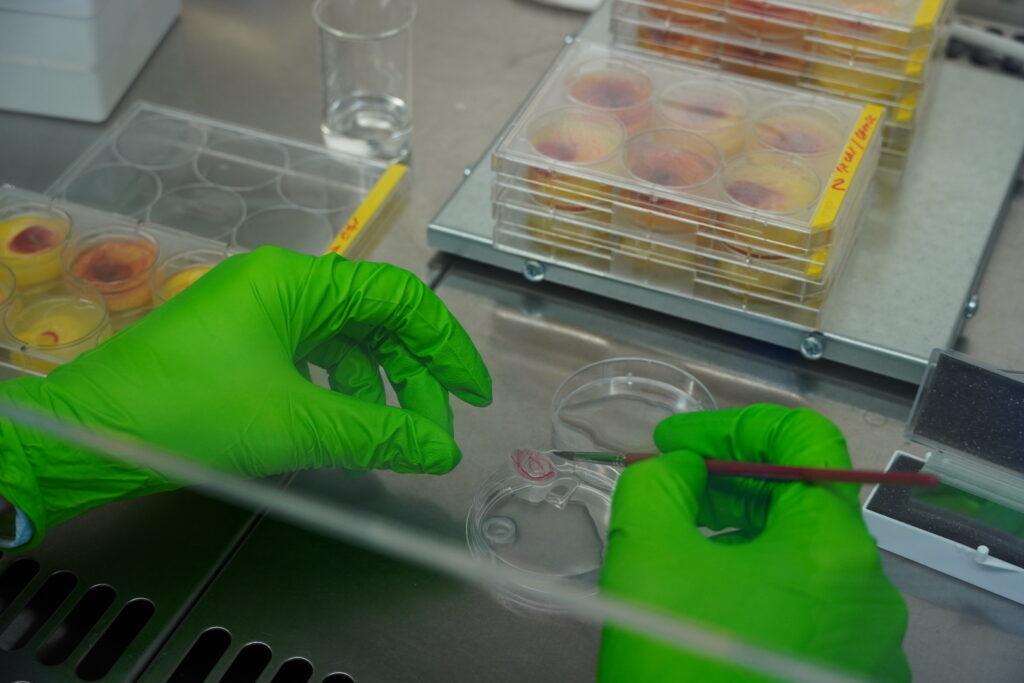
Výskumná skupina Molekulárna onkológia

ZAMERANIE
Výskumná skupina molekulárnej onkológie sa zameriava na štúdium nádorovej biológie a interakcie nádorových buniek s mikroprostredím, chemorezistenciu a metastázovanie solídnych nádorov. Väčšina tém sa skúma v spolupráci s klinickými pracovníkmi a využívajú sa modely, ako sú xenografty a organoidy odvodené od primárnych nádorových tkanív pacientov. Študujeme úlohu aldehyddehydrogenáz pri kolorektálnom karcinóme, skúmame epigenetickú dereguláciu pri uveálnom melanóme, zameriavame sa na prediktívne a prognostické markery a aplikáciu techník tekutej biopsie. Okrem toho skúmame úlohu mikroprostredia nádoru pri duktálnom adenokarcinóme pankreasu a rakovine prsníka. Naše predchádzajúce projekty boli zamerané na kombinované terapie cielené prostredníctvom nanonosičov. Na riešenie klinicky relevantných problémov v onkológii využívame kombinácie rôznych experimentálnych prístupov od molekulárnej biológie po animálne modely. Rezistencia u testikulárnych germinatívnych nádorov je hlavnou témou Laboratória pre translačný onkologický výskum, ktoré je spoločným pracoviskom BMC SAV v. v. i., Lekárskej fakulty Univerzity Komenského v Bratislave a Národného onkologického ústavu.
Fotogaléria

Vedúca výskumnej skupiny
Dr. Miroslava Matúšková sa venuje štúdiu nádorovej biológie, mechanizmom chemorezistencie a metastázovania solídnych nádorov. Pôsobí v BMC SAV od roku 2005. Magisterské štúdium absolvovala na Prírodovedeckej fakulte UK v odbore biológa, špecializácia virológia; doktorandské na Lekárskej fakulte UK v odbore imunológia. Okrem výskumnej činnosti sa venuje problematike využívania zvierat pre vedecké účely a zvyšovania pohody zvierat v biomedicínskom výskume.